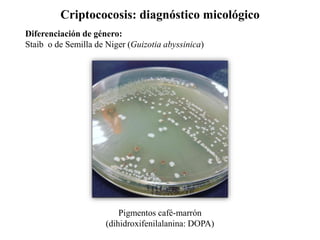
Criptococosis: diagnóstico micológico
Diferenciación de género:
Staib o de Semilla de Niger (Guizotia abyssinica)
Pigmentos café-marrón
(dihidroxifenilalanina: DOPA)
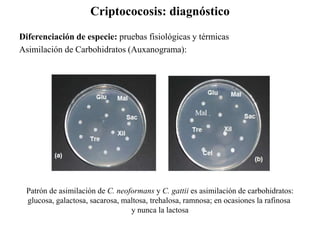
Criptococosis: diagnóstico
Diferenciación de especie: pruebas fisiológicas y térmicas
Asimilación de Carbohidratos (Auxanograma):
Patrón de asimilación de C. neoformans y C. gattii es asimilación de carbohidratos:
glucosa, galactosa, sacarosa, maltosa, trehalosa, ramnosa; en ocasiones la rafinosa
y nunca la lactosa

La criptococosis es una micosis oportunista causada por levaduras del género Cryptococcus, predominando las especies C. neoformans y C. gattii, siendo inhalatoria y con alta afinidad por el sistema nervioso central. La epidemiología muestra que C. neoformans afecta principalmente a individuos inmunocomprometidos, mientras que C. gattii puede infectar a personas con un sistema inmunológico aparentemente sano en áreas tropicales. El diagnóstico se basa en la observación de la cápsula y características de crecimiento del hongo en cultivos específicos.